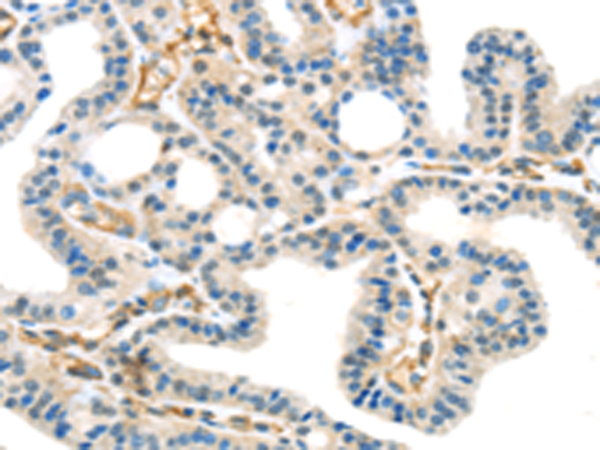

别名:CCDC99应用:IHC
反应种属:Human
规格:50μl/100μl
| Description |
|---|
| Required for the localization of dynein and dynactin to the mitotic kintochore. Dynein is believed to control the initial lateral interaction between the kinetochore and spindle microtubules and to facilitate the subsequent formation of end-on kinetochore-microtubule attachments mediated by the NDC80 complex. Also required for correct spindle orientation. Does not appear to be required for the removal of spindle assembly checkpoint (SAC) proteins from the kinetochore upon bipolar spindle attachment. |
| Specification | |
|---|---|
| Aliases | CCDC99 |
| Swissprot | Q96EA4 |
| Host/Isotype | Rabbit IgG |
| Storage | Store at 4°C short term. Aliquot and store at -20°C long term. Avoid freeze/thaw cycles. |
| Species Reactivity | Human |
| Immunogen | Synthetic peptide of human SPDL1 |
| Formulation | pH7.4 PBS, 0.05% NaN3, 40% Glycerol |
| Application | |
|---|---|
| IHC | 1/25-1/100 |
| ELISA | 1/2000-1/5000 |
 |
The image is immunohistochemistry of paraffin-embedded Human prostate cancer tissue using P05358(SPDL1 Antibody) at dilution 1/40. (Original magnification: ×200) |
|
The image is immunohistochemistry of paraffin-embedded Human thyroid cancer tissue using P05358(SPDL1 Antibody) at dilution 1/40. (Original magnification: ×200) |
本公司的所有产品仅用于科学研究或者工业应用等非医疗目的,不可用于人类或动物的临床诊断或治疗,非药用,非食用。
暂无评论
本公司的所有产品仅用于科学研究或者工业应用等非医疗目的,不可用于人类或动物的临床诊断或治疗,非药用,非食用。
 中文
中文 








发表回复